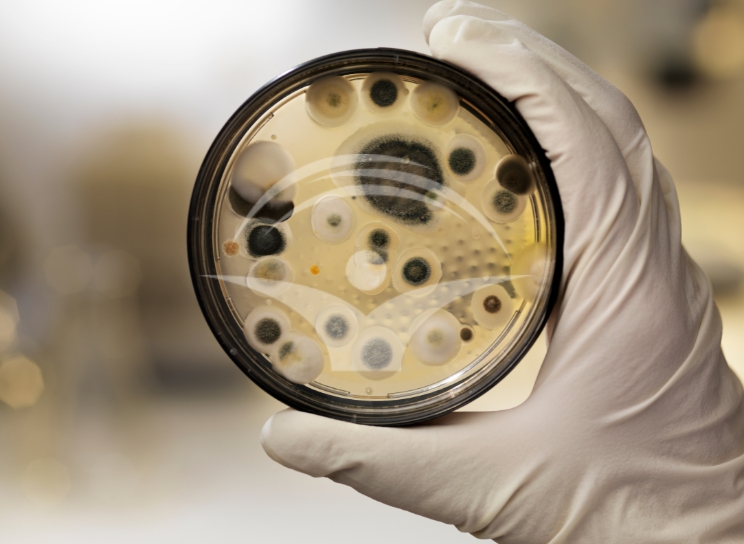

Expunerea la sporii de mucegai regasiti in aerul atmosferic creste riscul de aparitie al crizelor de astm bronsic la persoanele care sufera de acest tip de afectiune respiratorie. Expunerea repetata, consecventa la umezeala crescuta si la mucegaiurile care rezida in spatii inchise (domiciliu, loc de munca) este asociata riscului de aparitie al astmului bronsic la copiii de varsta mica si accentuarea simptomatologiei clinice la adultul cu aceasta afectiune.
Pe langa astm bronsic si rinita, expunerea repetata la fungi mai este asociata cu cresterea riscului de aparitie al micozei bronhopulmonare alergice, sinuzita alergica si pneumonita de hiperensibilitate.
Manifestarile clinice respiratorii care pot fi cauzate de expunerea la mucegaiuri includ, de regula:
- tuse (cu sau fara hemoptizie - sange)
- Congestie nazala
- Dispnee
- Wheezing (respiratie suieratoare).
Acestea pot fi insotite si de alte simptome de tipul durerii sinusale, sindromului febril, transpiratiilor nocturne, senzatiei persistente de oboseala si eruptiilor tegumentare.
Cuprins
- Ce sunt mucegaiurile?
- Unde se gasesc mucegaiurile?
- Alternaria alternata
- Aspergillus fumigatus
- Cladosporium herbarum
- Penicillium notatum
- Ce boli poate cauza sau agrava mucegaiul?
- Ce boli poate cauza/agrava mucegaiul la copii?
- Ce simptome apar in caz de alergie la mucegai?
- Cum ne dam seama daca avem o problema de sanatate cauzata de mucegai?
- Exista persoane predispuse la probleme de sanatate din cauza mucegaiurilor?
- Ce masuri de preventie putem lua?
Ce sunt mucegaiurile?
Fungii reprezinta microorganisme ubicvitare (se regasesc la tot pasul) care se raspandesc, in principal, pe cale aeriana sub forma de spori, micelii si fragmente de hife. Odata inhalate, aceste bioparticule pot contribui la aparitia mai multor tipuri de patologii atat la persoanele sanatoase, cat si la indivizii predispusi care asociaza o serie de factori de risc.
Unde se gasesc mucegaiurile?
In spatiile inchise, dezvoltarea mucegaiurilor este favorizata de umezeala crescuta care poate fi recunoscuta prin prezenta igrasiei ce implica umezeala persistenta retinuta in porii zidariei, exfolierea tencuielii, mirosuri neplacute si dezvoltarea mucegaiului sub forma de colonii extinse, vizibile cu ochiul liber. In acelasi timp, igrasia din incaperi favorizeaza dezvoltarea acarienilor si actinomiceteleor care pot cauza patologii specifice distincte.
Prezenta in aerul atmosferic din exterior al mucegaiurilor este evaluata cu ajutorul unor masuratori specifice care pot determina si cuantifica in acelasi timp tipul si cantitatea de bioaerosoli din atmosfera. Concentratia medie de spori din aerul atmosferic exterior este cuprinsa, de obicei, intre 50 spori/de aer in timpul sezonului rece si poate depasi 50.000 de spori / pe durata sezonului cald si umed.
In regiunile cu clima temperata sporii ating concentratia maxima la sfarsitul verii si se diminueaza odata cu scaderea temperaturilor si aparitia inghetului. Mucegaiurile se regasesc peste tot la nivelul globului chiar si in cele mai indepartate si izolate zone, sporii fiind transportati cu usurinta prin intermediul curentilor de aer care deplaseaza nori de praf/nisip formati in zonele calde.
Alternaria alternata
Fungusul Alternaria alternata a devenit recunoscut pentru prima data in 1817 sub denumirea de Alternaria tenuis. In 1930 a fost stabilita legatura de cauzalitate intre sporii acestuia si aparitia astmului alergic. Alternaria alternata reprezinta la momentul actual cea mai frecventa si abundenta specie de fungi care determina astm alergic, in special la populatia pediatrica, expunerea la sporii acestuia fiind asociata cu severitatea si persistenta simptomelor respiratorii.
Alternaria alternata este un mucegai care provine in principal din mediul extern si disemineaza in aerul cald si uscat in special la sfarsitul verii si inceputul toamnei insa rezida si in medii de interior umede insuficient ventilate.
Aspergillus fumigatus
A.fumigatus sunt raspanditi ubicvitar in mediu la nivelul solului, plantelor, aerului atmosefric, apei si al materiei organice aflate in descompunere. Aspergillus fumigatus face parte din clasa ascomicetelor, fungi care dezvolta micelii ramificate si se transmit prin conidiospori rezistenti la caldura, deshidratare, tratament chimic, radiatii. Dupa eliberare, sporii pot ramane viabili la nivelul aerului atmosferic timp de mai multe luni.
Acest tip de microorganisme este capabil sa produca patologii specifice de tipul micotoxicozei (apare prin ingestia de alimente contaminate cu spori de aspergillus), manifestari alergice, infectii superficiale la persoanele imunocompetente si de tip invaziv (multisistemic) la cele imunocompromise.
In literatura de specialitate cunt descrise mai multe forme clinice de aspergiloza care pot surveni la persoanele imunocompromise si include:
- Aspergiloza pulmonara invaziva acuta
- Traheobronsita
- Aspergiloza bronsica obstructiva
- Sinuzita acuta invaziva
- Aspergiloza cerebrala, cutanata
- Aspergilomul primar
- Aspergiloza pulmonara cronica necrotizanta
- Endocardita
- Esteomielita
- Infectii auriculare
- Endoftalmita.
Inhalarea sporilor de Aspergillus fumigatus pot cauza aspergiloza bronho pulmonara alergica ABPA, o afectiune inflamatorie a plamanului si a cailor respiratorii care se manifesta, mai ales, la pacientii cu astm bronsic in proportie de aproximativ 1-2% din cazuri si fibroza chistica 1-15%.
Cladosporium herbarum
Cladosporium herbarum rezida in principal in sol, plante si alimente (in special cereale), insa poate coloniza cu usurinta diverse suprafete din locuinta asa cum sunt filtrele de aer conditionat, guri de ventilatie si suprafata geamurilor. Beciurile, baile fara ventilatie, tapetul aplicat pe zidarie, covoarele, storurile de la geamuri, perdelele si mobila din locuinta reprezinta alte medii in care se poate dezvolta C.herbarum.
Principalele tipuri de patologii care pot fi declansate de expunerea la sporii de Cladosporium herbarum includ:
- Astmul alergic
- Rinita alergica
- Micoza pulmonara alergica
- Pneumonita de hipersensibilitate.
Aceste patologii pot surveni secundar expunerii la spori sau metaboliti ai fungilor, care dupa inhalare ajung la nivelul cailor respiratorii inferioare, declansand o reactie alergica de tip acut sau intarziat.
Penicillium notatum
Penicillium notatum este un fung cu raspandire larga in mediul inconjurator implicat, de regula, in infectii sistemice la indivizii imunocompromisi care pot include:
- Pneumonie
- Otomicoza
- Endoftalmita
- Keratita
- Endocardita
- Micoza invaziva.
Cunoscut si sub denumirea de Penicillium chrysogenum, P.notatum se regaseste la nivelul solului, al materiei organice aflate in descompunere si al lemnului arborilor, paine invechita, fructe si nuci, fiind distribuit mai frecvent in zonele cu clima semi-tropicala si blanda. In cazuri rare, P.notatum poate cauza la persoanele imunocompetente reactii alergice la nivel respirator cu exacerbarea astmului bronisc.
Ce boli poate cauza sau agrava mucegaiul?
Principalele patologii care pot fi cauzate sau acutizate de expunerea repetata la mucegai poate fi clasificata in conformitate cu tropismul patogenului pentru diferite tesuturi si organe ale corpului si
- Afectiuni respiratorii, otomicoza, onicomicoza si granuloame fungice la nivel cerebral in cazul Aspergillus candidus
- Sinuzita, keratita, aspergiloza, osteomielita in cazul expunerii la Aspergillus flavus
- Infectii pulmonare pentru Aspergillus fumigatus
- Otomicoza, aspergiloza pulmonara in cazul Aspergillus niger
- Aspergiloza invaziva, onicomicoza in cazul Aspergillus versicolor\Keratita, astm bronsic si pneumonie pentru Penicillium citrinum
- Fungemie, leziuni tegumentare si anemie pentru Penicillium marneffei.
Expunerea pe termen scurt la sporii de mucegai cauzeaza, de regula, fenomene respiratorii alergice tranzitorii care pot include:
- Congestie nazala si sinusala
- Prurit ocular
- Secretii oculare apoase
- Vedere in ceata
- Wheezing (respiratie suieratoare)
- Tuse
- Stranut
- Epistaxis (sangerare nazala)
- Eruptii tegumentare
- Cefalee
- Acutizari ale astmului bronsic.
Ce boli poate cauza/agrava mucegaiul la copii?
Manifestarile clinice de tip alergic care pot surveni secundar expunerii pe termen scurt a copiilor la mucegaiuri sunt similare celor intalnite la adulti. Pe termen lung, inhalarea sporilor de catre copil poate contribui la aparitia:
- Afectiunilor respiratorii (astm, sinuzita cronica, bronsita)
- Afectare neurologica (disfunctie cognitiva, tulburari de dispozitie)
- Diminuarea capacitatii de functionare a sistemului imun
- Oboseala cronica
- In cazuri severe, micotoxicoza cu manifestari multisistemice polimorfe.
Ce simptome apar in caz de alergie la mucegai?
Manifestarile clinice ale alergiei la mucegai includ:
- Rinoree (secretii nazale apoase)
- Congestie nazala
- Picatura postnazala (scurgerea secretiilor nazale la nivelul peretelui faringian posterior)
- Stranut
- Prurit nazal/ocular/auricular
- Edem palpebral
- Secretii oculare apoase.
In cazul persoanelor cu teren atopic preexistent, expunerea la mucegaiuri poate cauza aparitia manifestarilor clinice de astm alergic care se refera in principal la bronhospasm, tuse si dispnee.
Cum ne dam seama daca avem o problema de sanatate cauzata de mucegai?
Aparitia de simptome alergice dupa expunerea la umezeala si igrasia din spatiile inchise si la conditiile exterioare care preced furtunille cu descarcari electrice (vijelie care antreneaza bioparticule in aerul atmosferic) constituie principalul indiciu al existentei unei hipersensibilitati la cantitatile crescute de bioparticule in aerul inhalat. Simptomatologia clinica persistenta care nu poate fi atribuita unei patologii de fond specifice, necesita efectuarea unei anamneze amanuntite si al unui examen clinic exhaustiv care sa evidentieze conditiile de viata ale bolnavului.
Exista persoane predispuse la probleme de sanatate din cauza mucegaiurilor?
- Persoanele imunocompromise din diferite cauze (cancer hematologic, chimioterapie, radioterapie, tratamente corticosteroid/biologic, transplant de organ/tesuturi)
- Cele cu teren atopic (predispuse la alergii) sunt cele mai predispuse la infectiile cauzate de inhalarea fungilor din aerul atmosferic si asociaza risc crescut de evolutie sistemica a patologiei.
- Alaturi de acestia, copii, varstnicii si gravidele constituie alte categorii populationale cu risc crescut de dezvoltare al patologiilor cauzate de expunerea la mucegaiuri.
Ce masuri de preventie putem lua?
Principalele modalitati de prevenire a dezvoltarii mucegaiurilor in spatiile de inchise se refera la:
- Controlarea umiditatii din incaperi prin aerisirea regulata a camerelor si utilizarea dezumidificatoarelor
- Repararea corespunzatoare a instalatiilor care genereaza scurgeri de apa si cresc umiditatea in locuinta
- Igienizarea regulata a spatiilor cu utilizarea de produse special destinate pentru distrugerea sporilor de mucegai
- Monitorizarea calitatii aerului prin utilizarea filtrelor HEPA care sunt eficiente in reducerea numarului de bioparticule din aerul incaperilor.
Manifestarile clinice ale expunerii indelungate la mucegaiuri sunt polimorfe si uneori pot fi nespecifice putand include ceata mentala (brain fog), cefalee, senzatia de oboseala persistenta, eruptii tegumentare, tulburari de vedere, tuse cu hemoptizie sau manifestari digestive. In prezenta oricarui tip de simptome care nu pot fi corelate cu o anumita patologie de fond, medicul curant trebuie sa ia in considerare si o eventuala expunere la bioparticule si sa efectueze o anamneza amanuntita solicitand detalii despre stilul si conditiile de viata ale fiecarui pacient in funcție de fiecare caz in parte.
Referinte:
- Abordarea diagnostica moleculara in aspergiloza bronhopulmonara alergica
- Exposure and Health Effects of Fungi on Humans, Sachin N. Baxi, Jay M. Portnoy, Désirée Larenas-Linnemann, Wanda Phipatanakul
- Health Problems, CDC
- Health Risks Associated with Exposure to Filamentous Fungi, Mary Augustina Egbuta, Mulunda Mwanza, Olubukola Oluranti Babalola
- Mixed Pulmonary Infection with Penicillium notatum and Pneumocystis jiroveci in a Patient with Acute Myeloid Leukemia, Shervin Shokouhi, Shabnam Tehrani, Marjan Hemmatian
- Mold
- Mold Allergy, Asthma and Allergy Foundation of America (AAFA)
- Respiratory fungal allergy
- The Long-Term Health Effects of Mold Exposure
- When to see a doctor for mold exposure